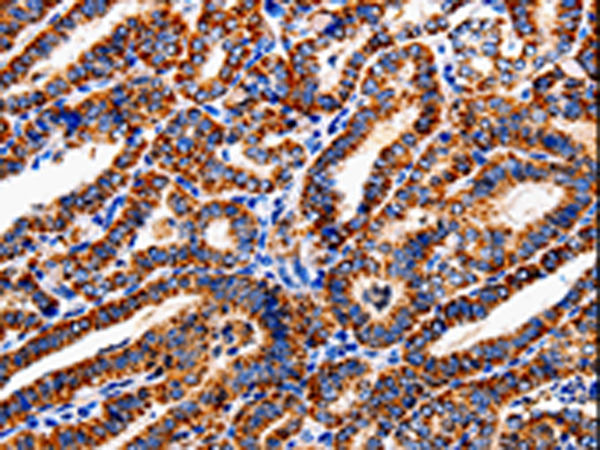

-
分类: 科研抗体货号: P00095别名: DWFC; JV5-1; MADH5应用: WB,IHC反应种属: Human, Mouse, Rat
-
分类: 科研抗体货号: P00099别名: SR; BCSG1应用: WB,IHC反应种属: Human
-
分类: 科研抗体货号: P00147别名: ANG3; ARP1; AngY; ANGPT3; UNQ162; dJ595C2.2应用: IHC反应种属: Human, Mouse
-
分类: 科研抗体货号: P00094别名: MGC104475应用: IHC反应种属: Human, Mouse
-
分类: 科研抗体货号: P00142别名: HTL-S-58j应用: WB,IHC反应种属: Human, Mouse, Rat
-
分类: 科研抗体货号: P00090别名: COXVB应用: WB反应种属: Human, Mouse, Rat
-
分类: 科研抗体货号: P00133别名:应用: WB,IHC反应种属: Human, Mouse, Rat
-
分类: 科研抗体货号: P00084别名: CD283; IIAE2应用: WB反应种属: Human, Mouse
-
分类: 科研抗体货号: P00130别名:应用: IHC反应种属: Human
-
分类: 科研抗体货号: P00082别名: CLG3, MANDP1应用: WB,IHC反应种属: Human, Mouse, Rat

鄂公网安备42018502007531号
鄂公网安备42018502007531号

